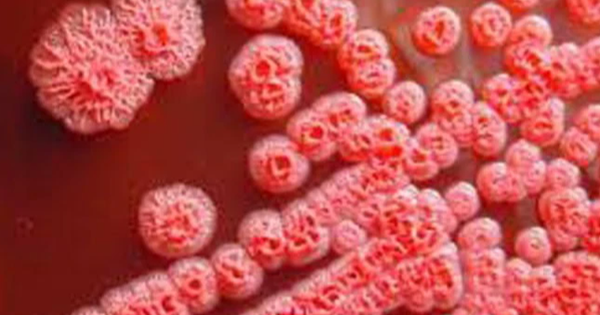
Bệnh Whitmore là một bệnh nhiễm trùng ở người và động vật do vi khuẩn Burkholderia Pseudomalle gây ra.

Bé gái 15 tuổi ở Thanh Hóa đã tử vong do mắc bệnh Whitmore
Ngày 19/9, ông Lê Đăng Khoa, Giám đốc Bệnh viện Nhi Thanh Hóa cho biết, bệnh nhi 15 tuổi (quê ở xã Tiên Trang, huyện Quảng Xương, tỉnh Thanh Hoá) mắc bệnh Whitmore đã tử vong dù được tích cực điều trị.
Điều tra dịch tễ cho thấy, từ ngày 22-30/8 vừa qua, bé gái có biểu hiện đau họng, ho, sốt cao, uống nhiều nước, sụt 7kg trong vòng 10 ngày, gia đình tự mua thuốc điều trị tại nhà nhưng không đỡ.
Ngày 1/9, gia đình đưa bé đến Phòng khám An Phúc ở xã Tiên Trang khám và lấy thuốc theo đơn về điều trị nhưng bệnh diễn biến ngày càng nặng với biểu hiện mệt mỏi, sốt cao, ăn uống kém...
Tiếp đó, người nhà đưa bé đến Bệnh viện 71 Trung ương làm các xét nghiệm cơ bản thì kết quả có chỉ số đường huyết cao, tiểu tiện không tự chủ, co giật toàn thân 2 cơn, mỗi cơn kéo dài 5-10 phút.
Ngày 4/9, bé gái được chuyển đến Bệnh viện Nhi Thanh Hóa trong tình trạng nguy kịch, suy tuần hoàn hô hấp, thở nấc, đồng tử 2 bên 3mm, nhịp tim không đều, nhanh, có nhịp ngoại tâm thu...
Sau khi tiến hành các xét nghiệm, bệnh nhi được phát hiện các chỉ số về bạch cầu, hồng cầu, định lượng Pro-calcitonin máu... đều tăng cao. Xét nghiệm cấy máu phát hiện bệnh nhi có vi khuẩn gây bệnh Brukholderia pseudomallei (bệnh Whitmore).
Theo đánh giá ban đầu, bệnh nhi bị viêm phổi nặng, suy gan, suy thận; có bệnh lý kèm theo là tiểu đường và béo phì. Bệnh nhi được điều trị hồi sức tích cực, thở máy, lọc máu, điều trị kháng sinh, điều chỉnh đường huyết.
Tuy nhiên, diễn biến bệnh ngày càng nặng. Bệnh nhi tử vong trong tình trạng suy đa tạng, phải lọc máu nhiều lần.
Trước đó, vào tháng 11/2022, tại Thanh Hóa cũng đã ghi nhận 2 bệnh nhân mắc Whitmore , trong đó trường hợp ở thị xã Nghi Sơn cũng đã tử vong trong tình trạng suy đa tạng, sốc nhiễm khuẩn, hoại tử ruột sau thời gian điều trị tại Bệnh viện Nhi Trung ương.
Bệnh Whitmore (tên gọi khác là bệnh Melioidosis) là một bệnh nhiễm trùng ở người và động vật do vi khuẩn Burkholderia Pseudomalle gây ra.
Vi khuẩn này sống trong đất, nước bị nhiễm khuẩn và xâm nhập vào cơ thể chủ yếu qua da khi có vết thương hở tiếp xúc trực tiếp.
Whitmore là bệnh không thường gặp, không gây thành dịch nhưng bệnh thường tiến triển nặng, có tỷ lệ tử vong cao, nhất là ở những đối tượng có nguy cơ cao.
Khi có nghi ngờ nhiễm bệnh, người dân cần đến cơ sở y tế để được tư vấn, khám phát hiện, xét nghiệm xác định nhiễm vi khuẩn Whitmore để được điều trị kịp thời.
Đọc tiếp cùng chuyên mục
Khi nào Bệnh viện Hữu nghị Việt Đức cơ sở 2 đi vào hoạt động?

Y tế 24h - 18/06/2026
Ngày 17/6, PGS.TS Dương Đức Hùng, Giám đốc Bệnh viện Hữu nghị Việt Đức, cho biết: Ngày 26/6, cơ sở 2 Bệnh viện Bạch Mai (phường Liêm Tuyền, tỉnh Nin...
Liên tiếp các ca sốt rét từ châu Phi trở về nhập viện

Y tế 24h - 17/06/2026
Ngày 16/6, Bệnh viện Bệnh nhiệt đới Trung ương thông tin, cảnh báo sau khi tại đây tiếp nhận nhiều bệnh nhân mắc sốt rét và đều từ các nước ở châu P...
Đà Nẵng: 43 người nghi ngộ độc sau khi ăn bánh mì, trong đó có 22 học sinh

Y tế 24h - 17/06/2026
Ngày 16/6, lãnh đạo Bệnh viện đa khoa khu vực Quảng Nam (TP Đà Nẵng) cho biết, bệnh viện đang điều trị cho 43 trường hợp nghi ngộ độc thực phẩm sau...
Nhiều loại sữa trẻ em bị thu hồi ở nước ngoài, Bộ Y tế yêu cầu rà soát

Y tế 24h - 16/06/2026
Theo Cục An toàn thực phẩm, Bộ Y tế, ngày 13/6, Cục Quản lý thực phẩm và dược phẩm Hoa Kỳ (FDA) đã ra thông báo về việc tự nguyện thu hồi toàn bộ cá...





